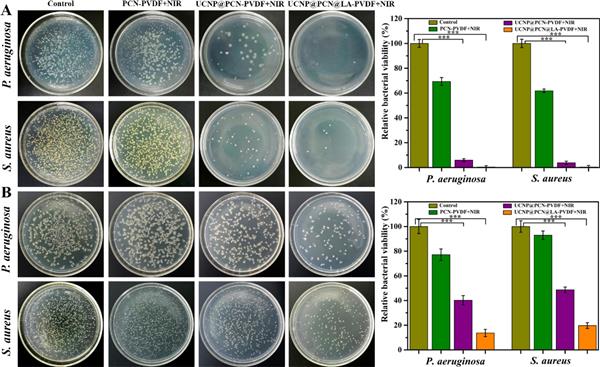

趙杰課題組納米抗菌論文"Near-infrared light triggered photodynamic and nitric oxide synergistic antibacterial nanocomposite membrane”高被引
課題組一篇納米抗菌方向的論文(Near-infrared light triggered photodynamic and nitric oxide synergistic antibacterial nanocomposite membrane)高被引。
Jing Sun a,c, Yong Fan b, Wei Ye c, Limei Tian a, Shichao Niu a, Weihua Ming d, Jie Zhao a,*,Luquan Ren a
在此,我們報道了一種納米復合聚偏氟乙烯(PVDF)膜,在單次 NIR 激發下具有 NO 輔助 PDT 抗菌性能,以提高治療效果。歡迎大家繼續關注。

文章鏈接:https://www.sciencedirect.com/science/article/pii/S1385894720341668?via%3Dihub
課題組圍繞仿生科學與工程學科,致力于仿生設計與制造,特別是仿生功能結構設計、醫用抗菌材料等領域,歡迎大家合作交流。
課題組網站:http://www.dpstg.com/ss/zhaojie1/index.html
文章簡介
作為一種新興的殺菌策略,光動力療法 (PDT) 在對抗各種病原體感染方面表現出巨大的潛力,但其抗菌效果可能會受到影響,這通常是由于其對短波長 (UV/Vis) 光的淺穿透性以及較短的擴散長度和產生的活性氧(ROS)的壽命。在此,我們提出了一種在單次近紅外 (NIR) 光照射下開發具有顯著增強殺菌性能的一氧化氮 (NO) 輔助 PDT 納米復合膜的方法。初步制備了由上轉換納米粒子 (UCNPs) 和卟啉 MOFs (PCN-224) 組成的分層結構納米粒子 (UCNP@PCN)。在摻雜 L-精氨酸 (LA) 后,將納米顆粒摻入聚偏二氟乙烯 (PVDF) 基質中,得到電紡納米復合膜 (UCNP@PCN@LA-PVDF)。 UCNP@PCN@LA-PVDF在近紅外光(980 nm)照射下,可以產生足夠的活性氧,不僅可以作為光動力治療的主要殺菌劑,還可以誘導負載的LA產生一氧化氮,最終實現一氧化氮輔助的光動力殺菌行為。與 ROS 相比,生成的 NO 表現出更大的殺菌面積,證明了在促進 PDT 抗菌功效方面具有重要的互補優勢,如體外和體內試驗所證明的那樣。這種類型的納米復合膜可能會發現獨特的生物醫學應用,其中需要高度增強的 PDT 抗菌效果和 NIR 光的深度穿透。
 圖Scheme 1. UCNP@PCN@LA-PVDF納米復合膜的制備及殺菌活性示意圖
圖Scheme 1. UCNP@PCN@LA-PVDF納米復合膜的制備及殺菌活性示意圖
 圖 1. (A, B) UCNPs 和 UCNP@PCN 的 SEM 照片。 (C, D) UCNP@PCN@LA-PVDF 的 TEM 和 SEM 圖像。 (E-G) UCNP@PCN@LA-PVDF 的元素映射(Yb 為綠色,Zr 為紫色,N 為藍色)。 (H) UCNP@PCN@LA-PVDF 的能量色散光譜儀 (EDS) 光譜。 (有關此圖例中顏色參考的解釋,請讀者參考本文的網絡版本。)
圖 1. (A, B) UCNPs 和 UCNP@PCN 的 SEM 照片。 (C, D) UCNP@PCN@LA-PVDF 的 TEM 和 SEM 圖像。 (E-G) UCNP@PCN@LA-PVDF 的元素映射(Yb 為綠色,Zr 為紫色,N 為藍色)。 (H) UCNP@PCN@LA-PVDF 的能量色散光譜儀 (EDS) 光譜。 (有關此圖例中顏色參考的解釋,請讀者參考本文的網絡版本。)
 圖 2. (A, B) UCNPs、PCN-224、UCNP@PCN 和 UCNP@PCN@LA 的 Zeta 電位和 TGA 曲線
圖 2. (A, B) UCNPs、PCN-224、UCNP@PCN 和 UCNP@PCN@LA 的 Zeta 電位和 TGA 曲線
 圖 3. (A) UCNPs、UCNP@PCN 和 UCNP@PCN@LA 納米粒子在 980 nm 激光激發下的上轉換發光 (UCL) 光譜, (B) UCNPs 的 UCL 光譜和 TCPP 的吸收光譜,這兩個光譜的重疊顯示為藍色。 (有關此圖例中顏色參考的解釋,請讀者參考本文的網絡版本。)
圖 3. (A) UCNPs、UCNP@PCN 和 UCNP@PCN@LA 納米粒子在 980 nm 激光激發下的上轉換發光 (UCL) 光譜, (B) UCNPs 的 UCL 光譜和 TCPP 的吸收光譜,這兩個光譜的重疊顯示為藍色。 (有關此圖例中顏色參考的解釋,請讀者參考本文的網絡版本。)
 圖 4. (A) 近紅外激光照射(功率 = 0.5 W)后 UCNP@PCN@LA-PVDF 中 DPBF 吸收光譜的變化。 (B) DPBF 在 410 nm 處的吸收強度作為不同樣品的時間函數。 (C) 不同組的 NO 釋放:UCNP@PCN@LA-PVDF + NIR、UCNP@PCN@LA-PVDF 和 UCNP@PCN-PVDF + NIR。 (D) UCNP@PCN@LA-PVDF 在重復開/關 NIR 照射下沒有釋放。
圖 4. (A) 近紅外激光照射(功率 = 0.5 W)后 UCNP@PCN@LA-PVDF 中 DPBF 吸收光譜的變化。 (B) DPBF 在 410 nm 處的吸收強度作為不同樣品的時間函數。 (C) 不同組的 NO 釋放:UCNP@PCN@LA-PVDF + NIR、UCNP@PCN@LA-PVDF 和 UCNP@PCN-PVDF + NIR。 (D) UCNP@PCN@LA-PVDF 在重復開/關 NIR 照射下沒有釋放。
圖 5. (A) 不同組銅綠假單胞菌和金黃色葡萄球菌的表面(接觸模型)抗菌活性。 (B) 不同組中銅綠假單胞菌和金黃色葡萄球菌的空間(附近模型)抗菌活性。
圖 5. (A) 不同組銅綠假單胞菌和金黃色葡萄球菌的表面(接觸模型)抗菌活性。 (B) 不同組中銅綠假單胞菌和金黃色葡萄球菌的空間(附近模型)抗菌活性。
 圖 6. (A) 附著在不同膜上的銅綠假單胞菌和金黃色葡萄球菌的 SEM 圖像,經過/不經過 NIR 處理(插圖比例尺為 500 nm)。 (B) 附著在不同膜處理的 PET 薄膜上的銅綠假單胞菌和金黃色葡萄球菌的 CLSM 圖像。 (C) NO輔助PDT抗菌策略的說明機制。
圖 6. (A) 附著在不同膜上的銅綠假單胞菌和金黃色葡萄球菌的 SEM 圖像,經過/不經過 NIR 處理(插圖比例尺為 500 nm)。 (B) 附著在不同膜處理的 PET 薄膜上的銅綠假單胞菌和金黃色葡萄球菌的 CLSM 圖像。 (C) NO輔助PDT抗菌策略的說明機制。

圖 7. (A) 不同處理 0、1、3、5 和 7 天后感染傷口的代表性照片(比例尺為 2.5 mm)。 (B) 在第 2 天從小鼠傷口中分離出的細菌。(C) 隨著時間的推移評估相對傷口面積。 (D) 不同處理 0、1、3、5 和 7 天后受感染小鼠的體重變化

圖 8 不同組治療后(A)H&E和(B)Masson''s trichome染色皮膚組織的顯微照片,藍色箭頭表示毛囊,黃色箭頭表示炎癥細胞,紅色箭頭表示新形成的血管. (有關此圖例中顏色參考的解釋,請讀者參考本文的網絡版本。)
總之,我們展示了一種 NIR 光誘導的納米復合膜,該膜具有來自 PDT 和 NO 的高效協同抗菌作用。在一步近紅外光照射下,所得的 UCNP@PCN@LA-PVDF 產生足夠的 ROS,既可以作為 PDT 中的殺菌劑,又可以通過與膜中的 LA 反應觸發 NO 的產生。與僅在 NIR 照射下產生 ROS 的 UCNP@PCN-PVDF 相比,UCNP@PCN@LA-PVDF 顯示出顯著增強的殺菌性能。其機制主要取決于生成的 NO 具有比 ROS 更大的擴散長度,如“接觸模型”和“附近模型”抗菌測試所示。此外,這種 NO 輔助的 PDT 膜可以抵抗炎癥并加速傷口愈合,這是由于 NO 具有顯著的協同抗菌性能和促進角質形成細胞增殖和成纖維細胞遷移的能力。細胞毒性測定表明,納米復合膜對哺乳動物細胞具有高細胞相容性。總體而言,這種 NIR 誘導的 NO 輔助 PDT 納米復合膜可以作為安全可控的生物醫學平臺,用于對抗各種病原菌污染和傷口感染。